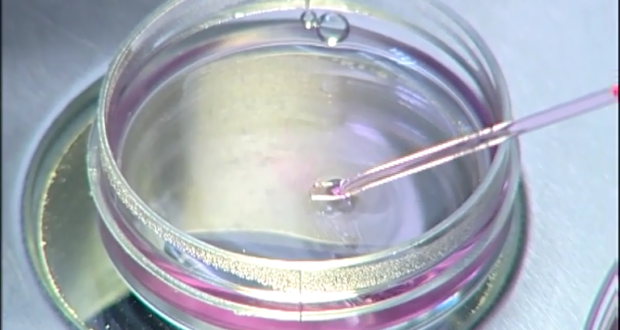

Warning: count(): Parameter must be an array or an object that implements Countable in /home/tupbebe4/public_html/wp-content/plugins/formcraft3/formcraft-main.php on line 1013
Tüp Bebek tedavisi ne kadar sürüyor?
Tüp bebek süresi, doktorun eşler için uygun gördüğü protokole göre değişiklik gösterir. Genelde tedavi süreci 15-18 gün arasındadır. (ilk ilaçların kullanılmaya başlamasından embriyo transferine kadar geçen süre).
Tüp bebek Tedavi Sırasında Hastanede Yatmam Gerekecek mi?
Hastanede kalacak durum yoktur. Sadece yumurtalar toplandıktan sonra ve embriyo transferi yapıldıktan sonra birkaç saat hastanede dinlenmeniz yeterlidir.
Yumurtalar Toplanırken Çok Ağrı Duyacak mıyım?
Hayır. Yumurta toplama işlemi sanılanın aksine çoğu hasta için rahatlıkla yapılan bir işlemdir. bazen de işlem hasta uyutularak gerçekleştirilmektedir.
Transferden Sonra Ne Zaman Yolculuğa Çıkabilirim?
Eğer eviniz işlemin yapıldığı tüp bebek merkezi ile aynı şehirde değilse, Embriyo transferi gününü merkezin bulunduğu yerde geçirip bir gün sonra evinize gidebilirsiniz.
Transfer Sonrası Gebelik Testinin Yapılacağı Zamana Kadar Devamlı Yatmam Gerekiyor mu?
Hayır. Herhangi bir ağrınız yoksa ve kendinizi iyi hissediyor iseniz zamanınızı yatarak geçirmek zorunda değilsiniz. Transferden bir gün sonra günlük yaşama dönebilirsiniz.
Tüp Bebek tedavisi ile dünyaya gelen bebekler sağlıklı mıdır?
Tüp bebek tedavisi ile doğan bebeklerin yapısal anormallikler, doğumsal anormallikler ve genetik anormallikler açısından doğal yolla oluşan bebeklerden önemli bir farklılık göstermediği bilinmektedir.
Tüp Bebek tedavisi riskleri ?
1. Yumurtalıkların aşırı uyarılması. 2. Belki de en büyük risk çoğul gebeliklerdir. 3. Son derece nadir de olsa yumurta toplama işlemi sırasında damar yaralanmalarına bağlı batın içi kanama veya işlemin bitmesinin ardından pelvik enfeksiyon izlenebilir.
Tüp Bebek Düşük İle Sonuçlanma Riski Daha mı Fazla?
Değildir. Normal yolla oluşan gebelikler ne kadar düşük riski taşıyor ise tüp bebekte de risk de aynıdır.
 Tüp bebek Fiyatları – ücretleri – maliyeti 2025 Tüp bebek Fiyatları – ücretleri – maliyeti 2025
Tüp bebek Fiyatları – ücretleri – maliyeti 2025 Tüp bebek Fiyatları – ücretleri – maliyeti 2025